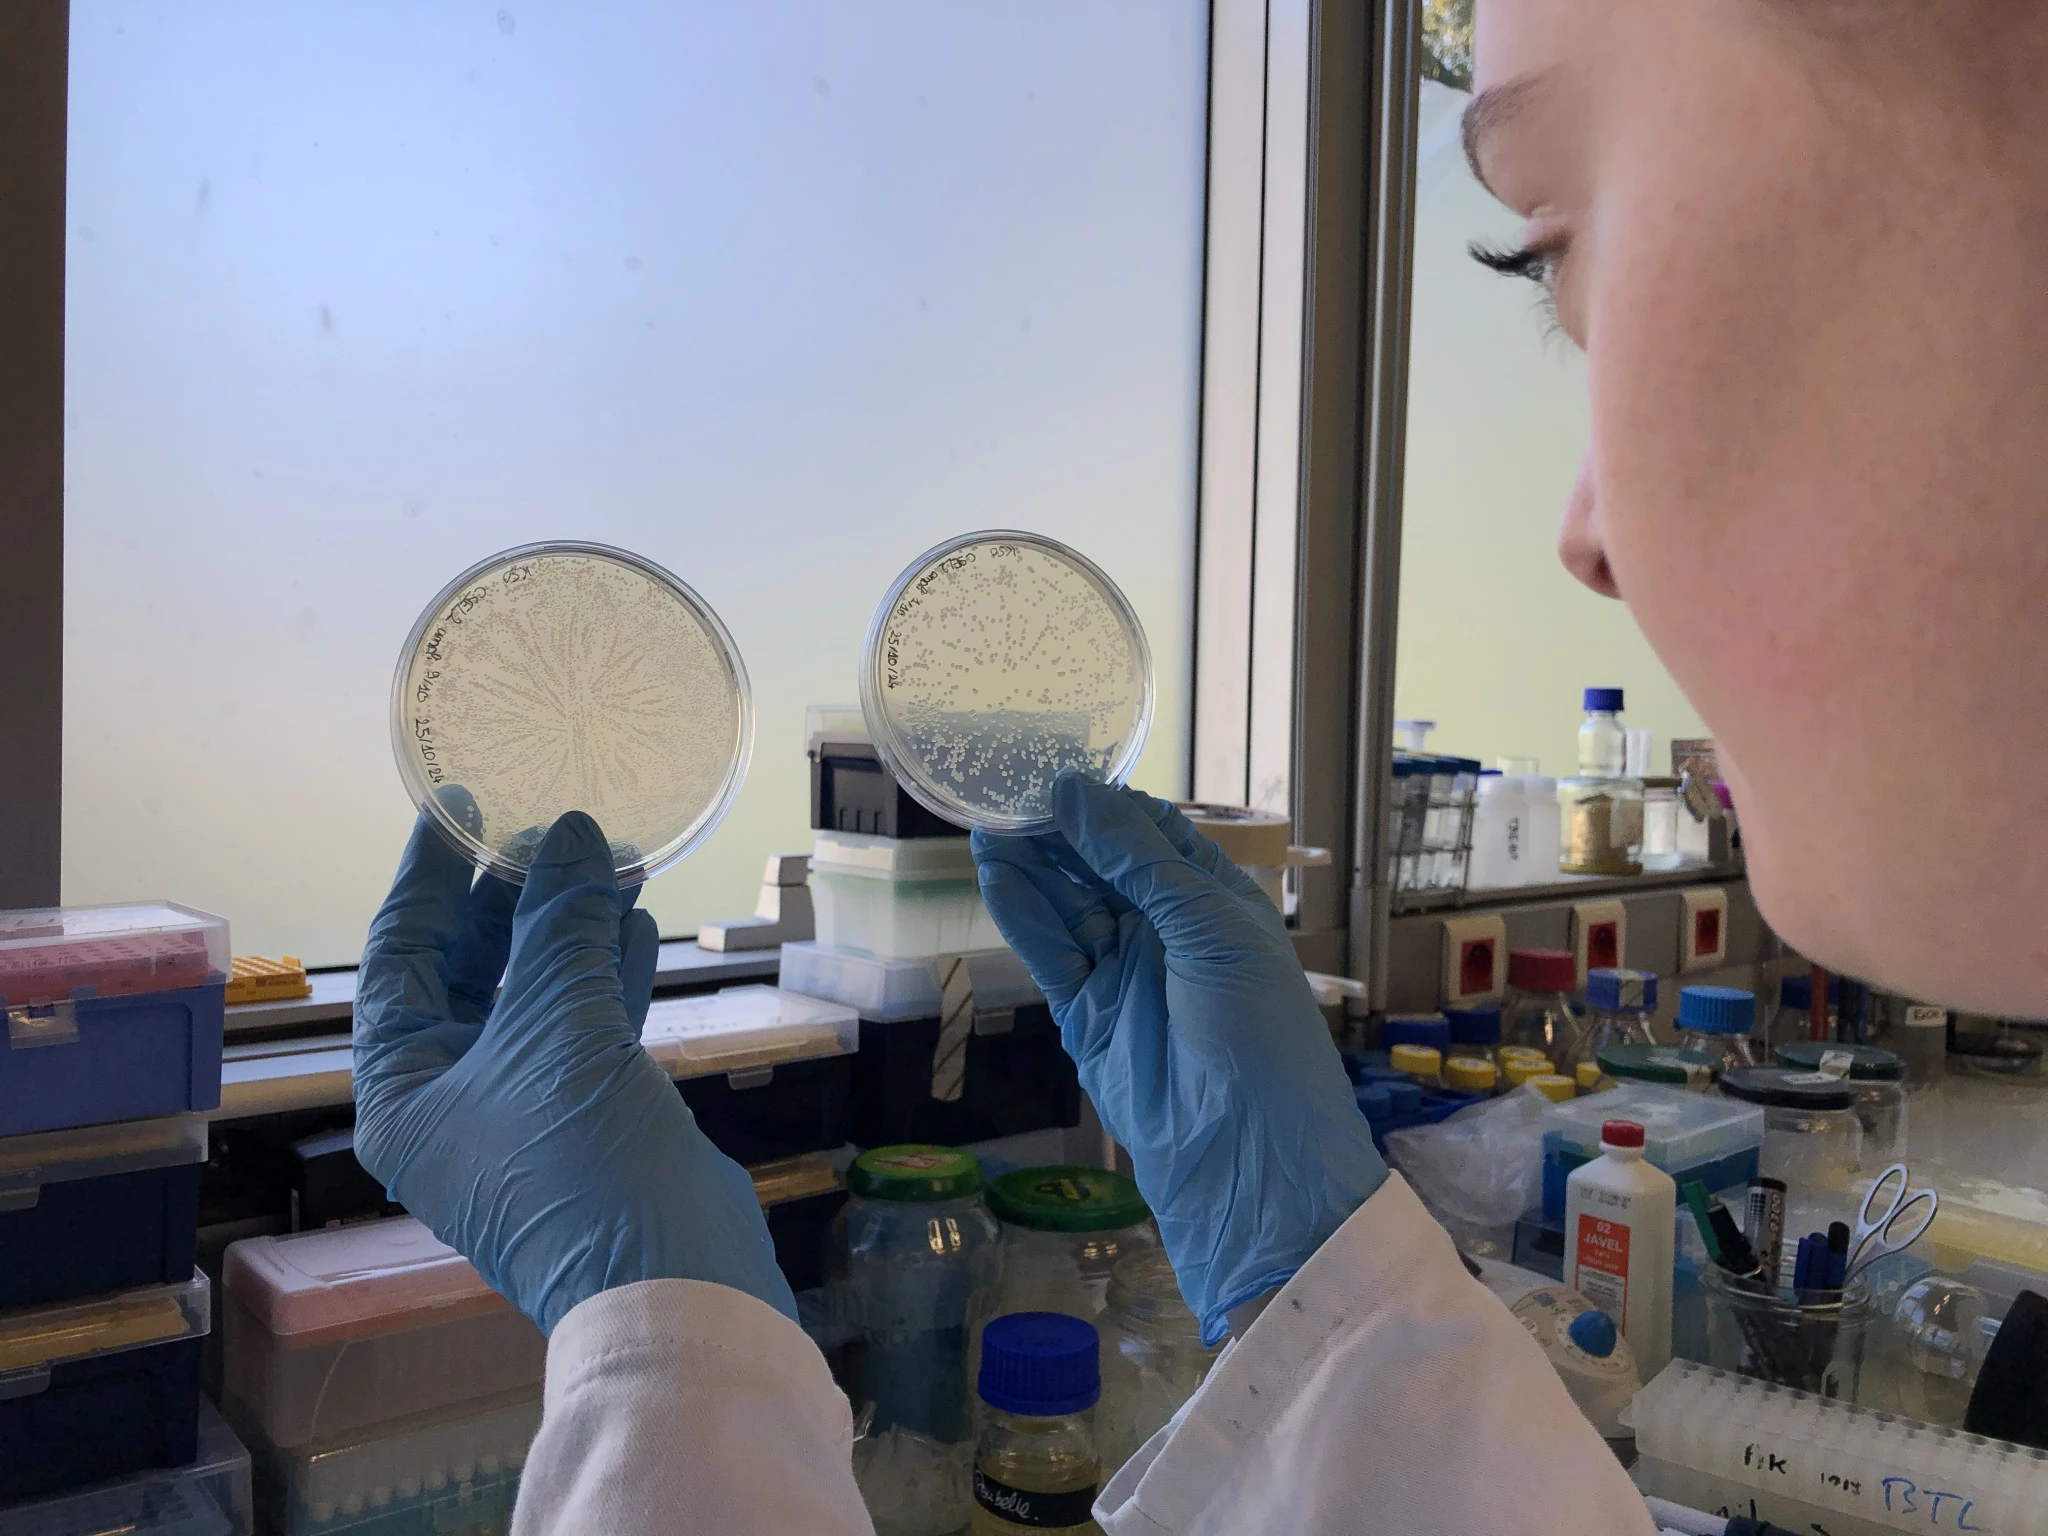

Plus belle la nuit avec les plantes bioluminescentes
Prédestiné ? Ghislain Auclair a créé les premières plantes bioluminescentes destinées à complémenter l’éclairage public et privé, avec sa compagne Rose-Marie. Leur start-up strasbourgeoise Woodlight est en phase de commercialisation des lumineuses pousses : bientôt la production !

Avis aux horticulteurs… à ceux qui se sont délocalisés hors des frontières de l’Union européenne (UE) surtout : la strasbourgeoise Woodlight recherche des producteurs pour ses plantes bioluminescentes, dans un futur très proche.
Les premiers prototypes, des plants de tabac bioluminescents dont la lumière émise est visible à l’œil nu, ont été observés au printemps 2024, après plus de cinq ans de recherche. Le miracle a eu lieu dans le laboratoire de la start-up, au Pôle API de l’Université de Strasbourg, à Illkirch-Graffenstaden. Le brevet a été déposé en septembre.
Voir ailleurs
Mais l’UE interdit, sans autorisation préalable, la mise sur le marché ou la dissémination dans l’environnement d’organismes génétiquement modifiés (OGM), ce que sont, sans surprise, les plantes bioluminescentes (lire encadré). L’autorisation n’a pas encore été obtenue par Woodlight. Ses plantes ne se mangent pas (digérées, elles n’émettront aucune lumière : aucun espoir d’étron fluo), ni ne se fument, et elles sont stériles. Aussi, il n’y a pas encore de culture en plein champ. Elles n’entrent, à première vue, dans aucune case prévue par le législateur.
Le rêve de Rose-Marie et Ghislain Auclair, les heureux parents des « plantes-lucioles », de voir des villes revégétalisées avec leurs compléments d’éclairage public et de balisage « fonctionnant » sans électricité, ni raccordement, recyclables à 100 % car compostables, et dépolluant l’atmosphère (les plantes absorbent du CO2), se réalisera donc peut-être hors de l’UE.
Une autonomie à un million
Qu’à cela ne tienne, les deux biologistes, fondateurs de la SAS Woodlight, lancent une levée de fonds d’un million d’euros pour accélérer la commercialisation de leurs « loupiottes végétales », qui peuvent aussi être purement décoratives.
« D’ici six mois, grâce aux moyens récoltés et à l’embauche de trois salariés supplémentaires (une équipe de six personnes travaille actuellement à Woodlight, ndlr), nous espérons que les plantes bioluminescentes seront autonomes, c’est-à-dire qu’elles n’auront pas besoin que nous les activions en ajoutant une molécule, pour produire des photons, donc de la lumière, comme c’est encore le cas aujourd’hui », admet Ghislain Auclair, le président de la start-up. Rose-Marie, elle, est directrice générale. « Bientôt, la molécule pourra être synthétisée par la plante elle-même, comme c’est le cas pour les méduses », ajoute le quadragénaire. En attendant, les prototypes ne sont activés que pour les investisseurs.
Plantes endémiques
Ghislain Auclair poursuit : « nous cherchons des spécialistes de l’éclairage, des industriels, pour leur donner un contrat de licence et déployer ces lampes parfaites ». Presque parfaites car elles sont bien un complément d’éclairage : l’intensité lumineuse dégagée par les plantes n’est à elle seule pas assez forte pour éclairer une ville.
Laissant planer le mystère, Ghislain Auclair conclut : « Nous sommes déjà en contact avec des horticulteurs et des pépiniéristes. L’an prochain, nous aimerions travailler sur des variétés de plantes différentes. Le tabac a été choisi pour le développement car il pousse vite, mais l’idée est de travailler avec des plantes endémiques. Nous attendons de savoir à qui nous allons vendre et où pour savoir lesquelles ».
Et la lumière fut
« En partant des meilleurs gènes existant dans la nature, produisant les molécules nécessaires à la luminescence, c’est-à-dire ceux de lucioles, poissons, champignons, nous donnons aux plantes la capacité d’être bioluminescentes. En laboratoire, nous allons apporter ces gènes dans une cellule végétale (un morceau de feuille cultivé sur une gélose, riche en sucres et en nutriments), puis nous allons régénérer, à partir de cette cellule, une plante entière, in vitro : la cellule va se différencier, recréer une nouvelle cellule, jusqu’à recréer une nouvelle plante. Ensuite, nous la repiquons », résume Ghislain Auclair.
La genèse du projet
L’idée de créer des plantes bioluminescentes, comme dans le film Avatar, est née dans l’esprit des époux Auclair en 2015 après un voyage aux États-Unis, à travers des mégalopoles de béton insomniaques. « Nous souhaitons montrer l’intérêt écologique et économique de nos plantes, d’autant plus qu’avec le bouturage, il est possible d’en produire plein ! », s’exclame Ghislain Auclair, passionné de génétique et d’univers fantastiques. Sa détermination est intacte. Elle a pourtant été mise à rude épreuve, depuis le début de l’aventure.
« En 2016, après quatre années de doctorat, Rose-Marie et moi avions deux ans de chômage pour voir venir. Nous avons sollicité la Région Grand Est et la Banque publique d’investissement (BPI), mais pour obtenir des subventions il fallait un business plan, etc. J’ai donc suivi un master d’ingénierie de projets innovants (IPI) à Strasbourg. Puis, nous sommes allés au CNRS car il nous fallait un laboratoire pour nos recherches. Mais les locations étaient chères », se souvient Ghislain Auclair.
Il enchaîne : « J’ai alors effectué un stage de six mois à l’Université. J’ai proposé de créer un laboratoire en biotechnologie. À la fin de cette période, la Ville et l’Université ont mis la main à la poche pour que ce laboratoire existe. En mars 2018, il a ouvert. Fin 2018, Rose-Marie et moi avions une première preuve de concept, avec une molécule en tube, prouvant que ça éclaire vraiment. En parallèle, je coordonnais le réseau de laboratoires, en électronique, en chimie, en design, etc. Fin 2019, la Région Grand Est pour un quart, et la BPI nous subventionnent : plus de 120 000 euros. L’incubateur d’entreprises Semia nous suit de 2019 à 2021. Début 2020, épidémie de Covid oblige, le labo ferme, alors que nous avions, enfin, du financement. J’y ai un accès très restreint. En 2022, nous tenons la preuve d’une cellule végétale bioluminescente, visible au microscope. Fin de cette année-là, une première levée de fonds permettant de recruter des personnes capables de passer de la cellule à la plante est lancée. À parts égales, nous recevons au total 500 000 euros d’un crowdfunding et de business angels. La BPI abonde encore. En 2023, nous recrutons deux employés. En janvier 2024, nous sommes cinq plus une stagiaire, dont la rémunération est subventionnée par l’Eurométropole. Nous l’embauchons l’été suivant. Mais moi, je ne me dégage toujours pas de salaire », retrace Ghislain Auclair. Il gagne sa vie en étant directeur de transfert de technologies à l’Institut du médicament de Strasbourg (IMS).
« Heureusement, depuis 2016, nous étions soutenus par le Réseau Entreprendre et Henri-Pierre Michaud, dont sa boîte de coaching D’un pas décidez. On nous disait de partir à l’étranger, d’enseigner, notamment nos proches qui se souciaient de notre avenir. Sans appuis extérieurs, nous aurions sans doute été dépassés », pense Ghislain Auclair.